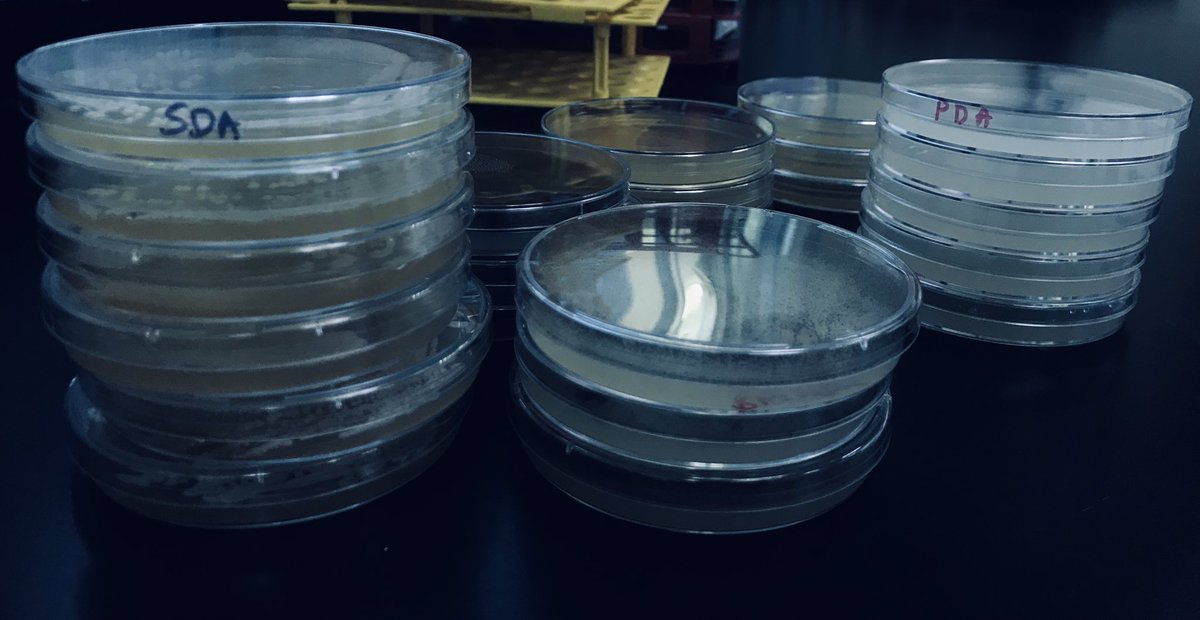
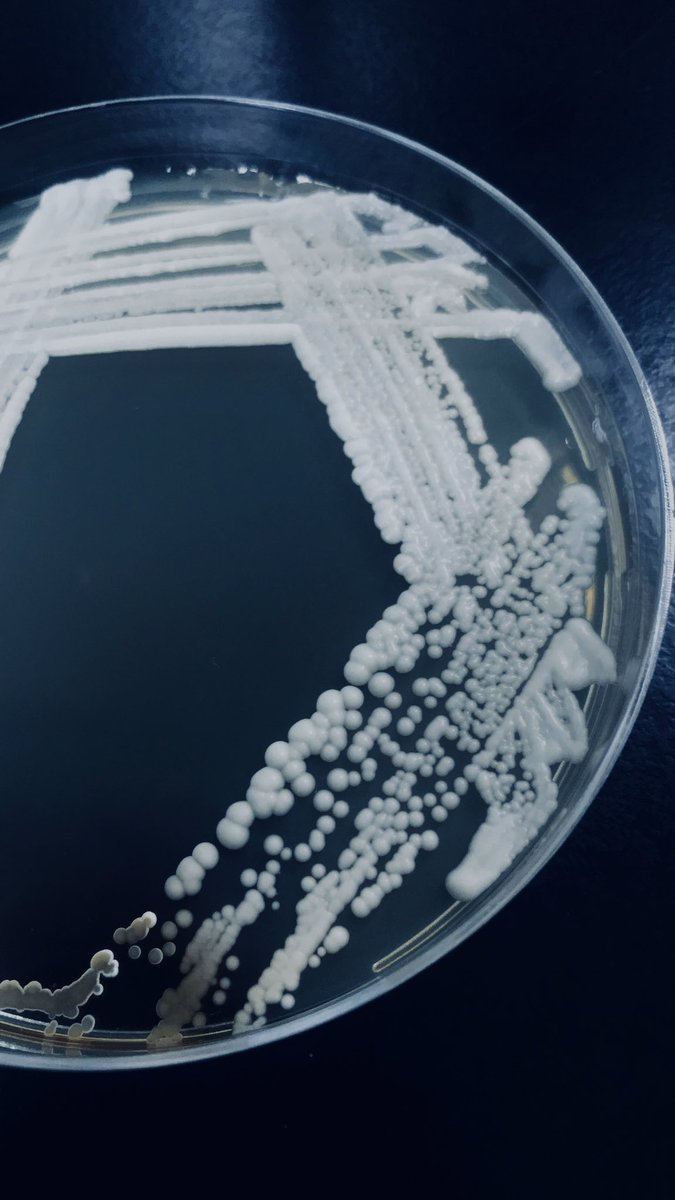
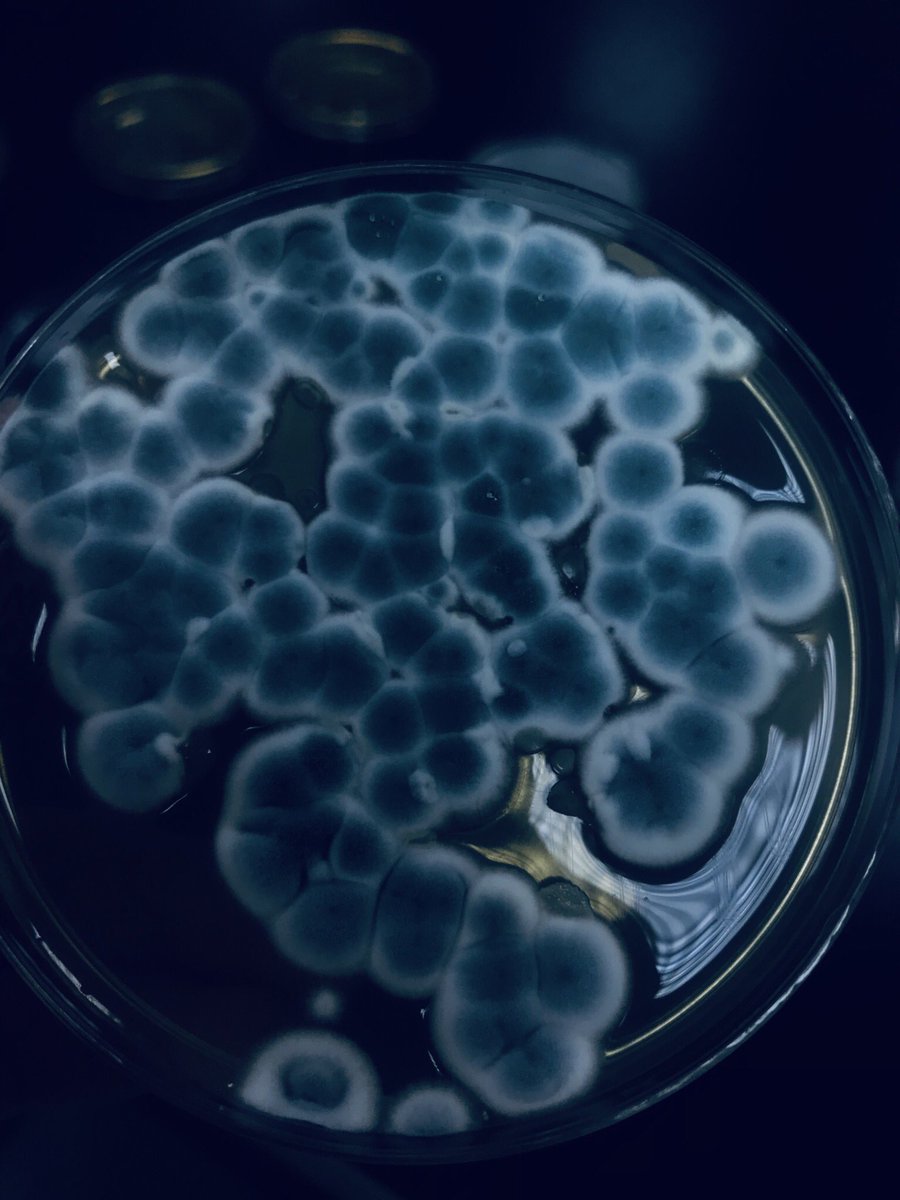
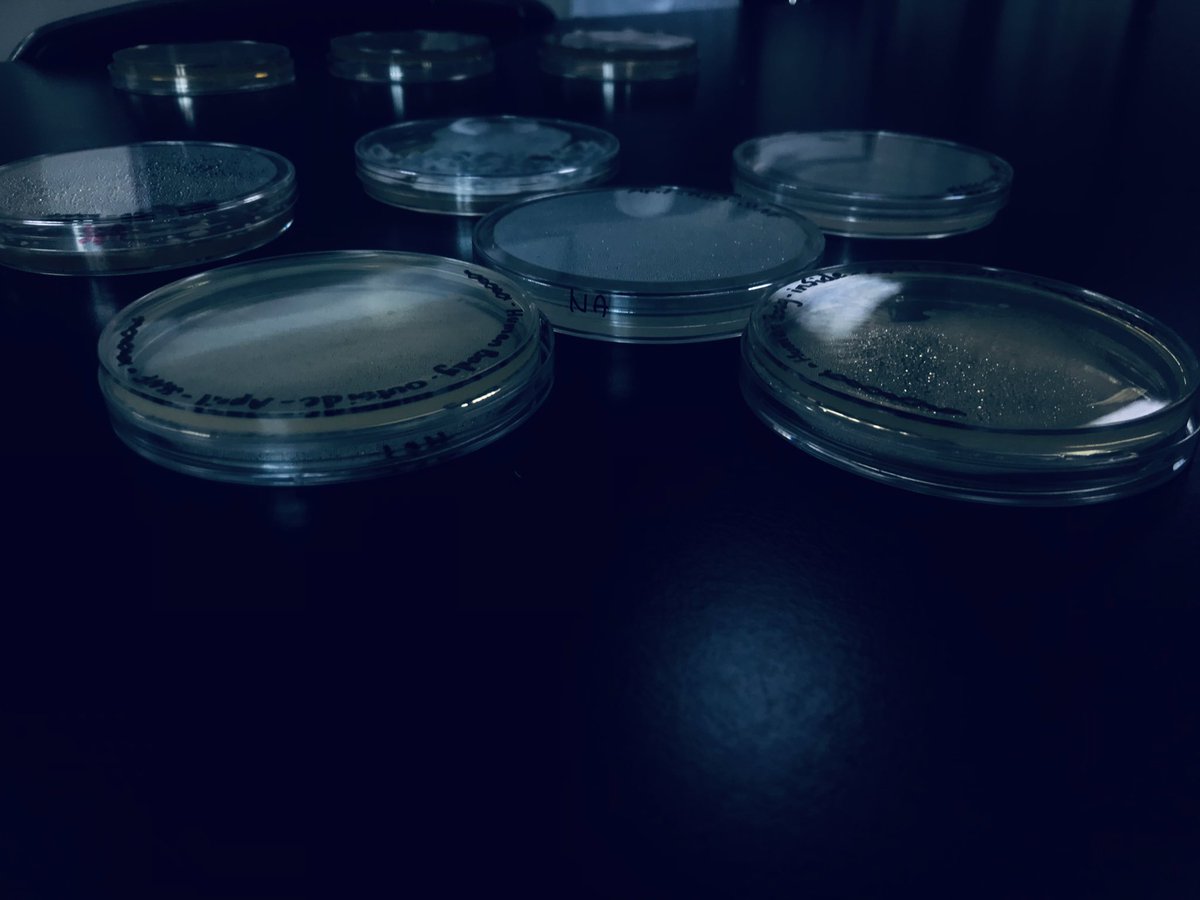
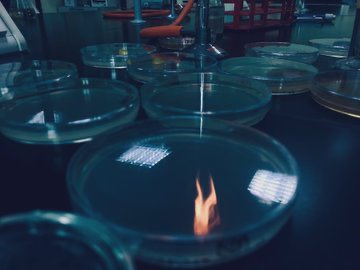

كلام من دكتور عندنا في التخصص🧬: youtu.be
شلون تخصصتي كنتي تعرفين التخصص؟
كلية العلوم إذا دشيتوها راح تشوفونها جنة و آنا مسؤولة عن الوصف كل الي يقولون لكم مقبرة هذيل ناس أساسًا يمكن مو داشينها عن حب و لا شغفهم هالنوع من العلم، فـ كلية العلوم تطلب منكم تصكرون أذونكم و واثق الخُطىٰ إلي يدري شنو دربه يدري إن يقدر و محد يقدر يأثر🥰!
إذا طقيتوا علىٰ صورتها👇🏻 تطلع لكم كل سوالفي و مواضيعي العلمية توصلكم بشكل أكبر عن أفكار التخصص🔍
و في النهاية أقول :
" أيها الناس إنه لا كنز أنفع من العلم "
" زَكَاةُ الْعِلْمِ نَشْرُهُ "
- الإمام علي (ع)
الله يبارك بعلمكم جميعًا و الله يخليه شفيع لكم علىٰ كل حرف يا رب، و تذكروه إن مرارة الجهل جدًا أقسىٰ من أي تعب فيه حلاوة العلم🤍!
" أيها الناس إنه لا كنز أنفع من العلم "
" زَكَاةُ الْعِلْمِ نَشْرُهُ "
- الإمام علي (ع)
الله يبارك بعلمكم جميعًا و الله يخليه شفيع لكم علىٰ كل حرف يا رب، و تذكروه إن مرارة الجهل جدًا أقسىٰ من أي تعب فيه حلاوة العلم🤍!
@a93_sara نفس جمالچ😂💜
@7ananii174 صدقيني معرفتچ الكنز يا حنان❤️❤️❤️❤️!!
جاري تحميل الاقتراحات...